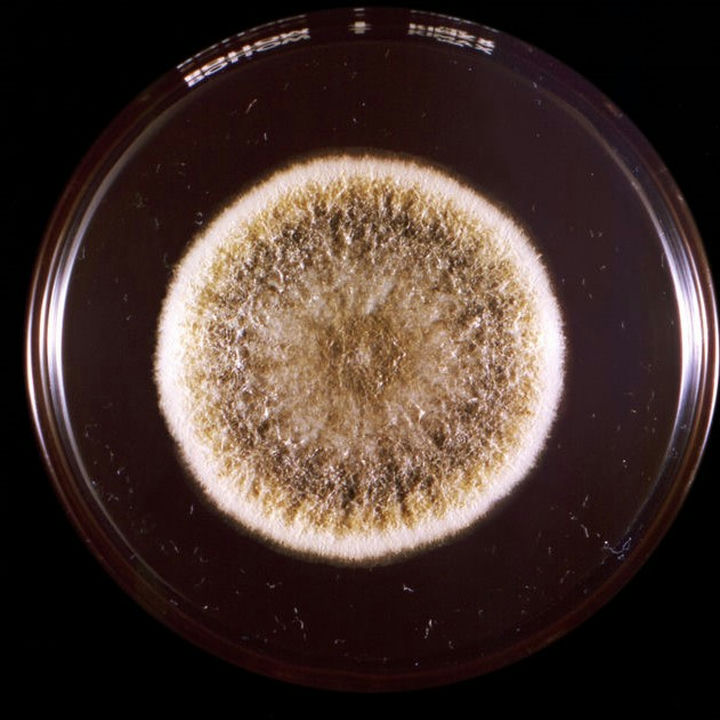

微信掃描二維碼,點擊右上角 ··· 按鈕
轉發給朋友或分享到朋友圈
顯微成像·洞察微觀之美
Microscopic imaging, insight into the beauty of micro
【科普】顯微鏡帶您認識不同種類的真菌
發布時間:2025-11-04
訪問量:51
真菌是廣泛存在于自然界的一類真核細胞生物,具有真正的細胞核和細胞器,不含葉綠素,以寄生和腐生方式吸取營養,能進行有性和無性繁殖。全世界已記載的真菌有10萬種以上,只有少數真菌與人類疾病有關。觀察真菌需要用到生物顯微鏡或者熒光顯微鏡,下面我們用熒光顯微鏡帶大家看幾組真菌圖片,看看您認識多少?
一、白念珠菌

培養皿中的白念珠菌

白念珠菌呈圓形或者卵圓形

在熒光顯微鏡下,觀察白念珠菌常單個出芽,有假菌絲者末端縮窄附于菌上,似“香腸”樣連接,菌絲多有分隔。
二、黃曲霉
培養皿中看到,菌落生長較快,結構疏松,表面灰綠色,背面無色或略呈褐色。

在顯微鏡明場觀察下,呈粗毛毯狀或放射狀皺紋,分生孢子頭疏松放射狀,黃色、黃綠色和棕綠色

在熒光顯微鏡下,可見“雙異型的45度分支”,菌絲較大,菌體有許多復雜的分枝菌絲構成,紫外激發下有藍色和綠色熒光。
三、煙曲霉

在培養皿中觀察,呈絨狀或絮狀邊緣,暗煙綠色

在生物顯微鏡下,煙曲霉呈現平滑薄壁的菌絲,頂囊瓶狀,分生孢子梗短

在熒光顯微鏡下,煙曲霉的頂囊清晰,熒光成像信噪比高、對比度強
四、黑曲霉

在培養皿中菌落厚絨狀、白色、黃色,局部黑色

在生物顯微鏡下,分生孢子為球形,菌絲發達,有隔膜和多分枝,頂部形成球形頂囊
五、新生隱球菌

在培養皿中觀察,菌落初呈白色,1周后轉淡黃或棕黃、濕潤粘稠,狀似膠汁,因為菌落新舊顏色差異會形成深色主體+淺色外環。

在生物顯微鏡明場觀察,呈球形或橄欖球形,菌體直徑4-20um,莢膜寬3-5um,不易染色。

在熒光顯微鏡下,煙曲霉的熒光成像信噪比高,有清晰暈圈;暈圈內可見菌體。
免責聲明
本站無法鑒別所上傳圖片、字體或文字內容的版權,如無意中侵犯了哪個權利人的知識產權,請來信或來電告之,本站將立即予以刪除,謝謝。
微信掃描二維碼,點擊右上角 ··· 按鈕
轉發給朋友或分享到朋友圈